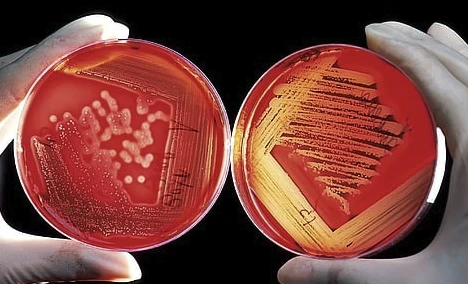
image.

基因组学
微生物基因组学,一般是指利用高通量测序技术和分子生物学技术,以特定环境样本中16S/ITS等扩增子或全部微生物的基因组为研究对象,采用生物信息学的分析方法,研究样本中微生物的组成及变化,并探讨环境因子等其他因素对其影响。微基生物提供扩增子测序、宏基因组测序、全基因组测序、菌种鉴定等各项服务。

扩增子测序
扩增子测序
微基生物利用二代高通量测序平台对土壤、水体、粪便、肠道内容物、唾液、皮肤等样本中的16S rRNA基因/18S rRNA基因/ITS/功能基因等进行检测,检测样本中微生物的种类和相对丰度。

扩增子定量检测
扩增子定量检测
扩增子定量检测将高通量测序(相对丰度)与qPCR绝对定量结合分析,增加样品间的可比性,揭示生物量水平的种群结构和功能改变,能反映样本中物种的真实数量和组间样本的真实差异,是进行微生态研究的首选。

宏基因组
宏基因组
宏基因组是指特定环境中全部微生物遗传物质的总和。宏基因组测序以特定环境中的整个微生物群落作为研究的对象,不需对微生物进行分离培养,而是提取环境微生物总DNA进行研究。

全基因组
全基因组检测
细菌全基因组检测,是指通过基因组测序和组装获得细菌全基因组序列,并对其进行结构和功能研究的方法。全基因组测序包含微生物的全部遗传信息。
菌种鉴定
菌种鉴定
微基生物专注微生物多样性研究,为高校、医院、研究所等单位提供科研服务。不仅可以检测土壤、水体、粪便、肠道内容物等样本中混合微生物的种类及丰度,而且还可以提供细菌、真菌等纯菌的菌种鉴定服务。